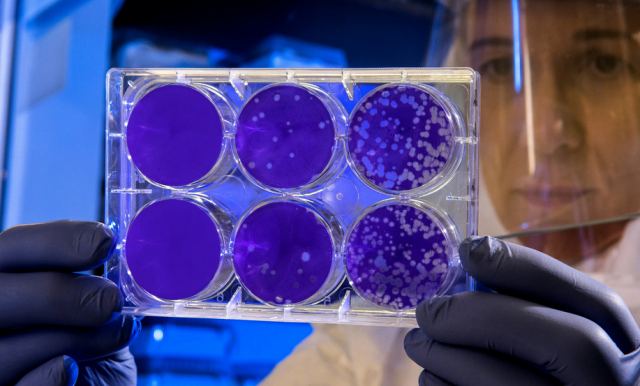
Σε έξαρση ο κοκκύτης - Γιατί στοχεύει παιδιά και εγκύους

Η διστακτικότητα απέναντι στα εμβόλια εξακολουθεί να αποτελεί το μεγαλύτερο εμπόδιο για τη Δημόσια Υγεία και σε αυτή την περίπτωση για την έξαρση του κοκκύτη
Κοκκύτης
Είναι ενδεικτικό ότι από τα 959 κρούσματα κοκκύτη που αναφέρθηκαν στη χώρα μας την περίοδο 2004-2024, τα 440 καταγράφηκαν το 2024
Τους πρώτους επτά μήνες του 2025 στις ΗΠΑ καταγράφηκαν 18.595 κρούσματα κοκκύτη εκ των οποίων τα 128 απεδείχθησαν μοιραία.